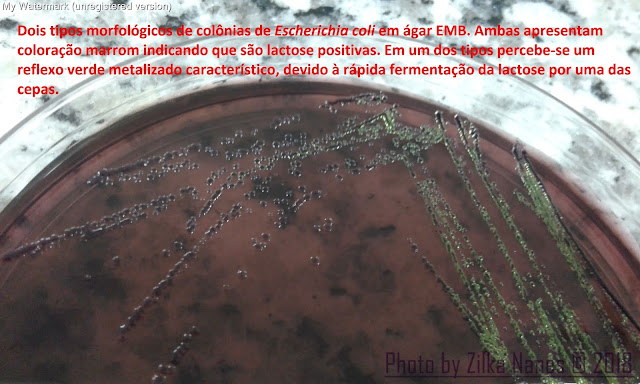

9. MORFOLOGIA DE COLÔNIAS DE MICRORGANISMOS
Como referenciar esta página: Nanes-Lima, Z.; Vieira, R.C.R., Silva, L.S. Morfologia de colônias de microrganismos. Detalhes Microbiológicos, Campina Grande, 10 nov. 2025. Disponível em: https://microimunoliga.blogspot.com/2016/08/pratica-9.html
![]() |
| Fonte: https://focusfoto.com.br/ |
(Microbiologia Básica / Profa . Zilka Nanes Lima)
Página atualizada em 10/11/2025
Creative Commons(by-nc-nd) ZILKA NANES LIMA(2025).
Atribuição-NãoComercial-SemDerivações.
IDENTIFICANDO BACTÉRIAS E Candida spp.
A. Primeiro passo: Isolar o micro-organismo em meio de cultura sólido e fazer a análise morfológica da colônia.
--------------------------------------------------------------------------------------------------------------------------
--------------------------------------------------------------------------------------------------------------------------
Análise morfológica da colônia (Utilizar os espaços que seguem para
anotar a interpretação destas características e ao final sugerir o possível
gênero e/ou espécie do micro-organismo).
Meio de
cultura: _______________________ Densidade: _________________________
Tamanho/Odor:
_______________________ Cor:
_______________________________
Borda ou
forma:_______________________ Consistência/Aparência: _______________
Elevação:____________________________ Hemólise em ágar Sangue: _____________
Sugerir qual
é o micro-organismo: _____________________________________________
Figura 2 - Cultura em ágar Sangue, meio sólido não seletivo, de Streptococcus mutans (alfa-hemolítico),
incubado à 36ºC em microaerofilia por 24 horas em estufa bacteriológica.
![]() |
| Fonte: Nanes-Lima (Arquivo pessoal) |
Tabela 1 - Características
do crescimento de alguns micro-organismos.
Micro-organismo
|
Tamanho /
Odor
|
Borda ou
forma
|
Elevação
|
Densidade
|
Cor
|
Consistência/
Aparência
|
Hemólise
em AS
|
Staphylococcus aureus
|
Grande
/Queijo
|
Circular
|
Convexa
|
Opaca
|
Amarela ou
branca
|
Cremosa
|
Em geral
beta
|
Staphylococcus coagulase-negativa
|
Médio
/Queijo
|
Circular
|
Elevada
|
Opaca
|
Branco-acizentada
|
Cremosa
|
Em geral
sem
|
Streptococcus do grupo viridans
|
Pequeno
/Caramelo
|
Irregular,
puntiforme
|
Achatada
|
Opaca
|
Branco-acizentada
|
Embaçada
|
Alfa
|
Streptococcus pneumoniae
|
Pequeno
|
Circular
|
Umbilicada
Achatada
|
Transparente
|
Cinza
|
Brilhante
Mucóide
|
Alfa
|
Streptococcus pyogenes
|
Pequeno
|
Puntiforme
|
Convexa
|
Translúcida
|
Cinza
|
Brilhante
|
Beta
|
Streptococcus agalactiae
|
Médio
|
Circular
|
Convexa
|
Translúcida
|
Cinza
|
Cremosa
|
Beta
|
Enterococcus faecalis
|
Médio
/Caramelo
|
Circular
|
Elevada
|
Opaca
|
Cinza
|
Brilhante
|
Em geral
sem
|
Enterobacter spp.
|
Médio
/Fermento de pão
|
Circular
|
Convexa
|
Opaca
|
Cinza(AS)
Rosa(MC)
|
Levemente
mucóide
|
Sem
hemólise
|
Escherichia coli
|
Médio
/Vinagre
|
Circular
|
Achatada
|
Opaca
|
Cinza (AS)
Rosa(MC)
|
Seca Brilho verde metálico (EMB)
|
Em geral
beta
|
Klebsiella spp.
|
Grande
/Fermento de pão
|
Circular
|
Convexa
|
Opaca
|
Cinza(AS)
Rosa(MC)
|
Mucóide
|
Sem
hemólise
|
Morganella morganii
|
Médio
/Fétido
|
Ondulada
|
Achatada
|
Translúcida
|
Incolor
(MC)
|
Brilhante
|
Sem
hemólise
|
Salmonella spp.
|
Pequeno
/Fétido
|
Circular
|
Convexa
|
Translúcida
|
Centro
preto(SS)
Incolor(MC)
|
Brilhante
|
Sem
hemólise
|
Serratia spp.
|
Médio
/Fermento de pão
|
Circular
|
Convexa
|
Opaca
|
Cinza(AS)
Clara(MC)
|
Levemente
mucóide
|
Sem
hemólise
|
Providencia spp.
|
Médio
/Fétido
|
Ondulada
|
Achatada
|
Translúcida
|
Incolor
(MC)
|
Brilhante
|
Sem
hemólise
|
Proteus spp.
|
Médio
/Fétido
|
Ondulada
|
Achatada
|
Translúcida
|
Incolor
(MC)
|
Brilhante
|
Sem
hemólise
|
Pseudomonas aeruginosa
|
Médio
/Uva
|
Irregular
|
Achatada
|
Transparente
|
Incolor
(MC). Pigmento esverdeado.
|
Brilhante
|
Com ou
sem.
|
Candida spp.
|
Médio
/Pão
|
Circular,
filamentosa
|
Elevada
|
Opaca
|
Branca
|
Cremosa
|
Sem
|
AS=
Agar sangue; MC=Agar MacConkey; SS= Agar Salmonella-Shigella;
Tamanho
das colônias (mm) : Grande = maior que 1 mm de diâmetro (Ex: Klebsiella pneumoniae)
Média = 1 mm de diâmetro (Ex: Enterococcus faecalis)
Pequena
= menor que 1 mm de diâmentro (Ex: Streptococcus
pyogenes)
Fonte: Oplustil et al., 2010 (com modificações feitas pela autora)
Fonte: Oplustil et al., 2010 (com modificações feitas pela autora)
--------------------------------------------------------------------------------------------------------------------------
B. Segundo passo: Realizar o GRAM da colônia.
1. Confeccionar o esfregaço, fixar o esfregaço na chama do bico de Bunsen;
2. Dispor as lâminas em um suporte não muito próximo uma de outra;
3. Cobrir o esfregaço com papel de filtro;
4. Cobrir o papel de filtro com cristal violeta e deixar por 1 minuto;
5. Lavar com água corrente, retirando o papel de filtro e o excesso do corante;
6. Cobrir o esfregaço com Lugol fraco por 1 minuto;
7. Lavar com água corrente;
8. Descorar com álcool-acetona, primeiro cobrindo o esfregaço deitado no suporte durante 10-20 segundos, e depois gotejando a lâmina inclinada até que não escorra mais o cristal violeta (cuidado para não descorar demais). PS: Pode se utilizar apenas álcool a 95% ou acetona;
9. Lavar com água corrente;
10. Cobrir com fucsina ou safranina por 30 segundos diluidas 1/10 (se o corante foi novo deixar um tempo ainda menor)
11. Lavar com água corrente e secar ao ar ou com papel de filtro;
12. Examinar ao microscópio.
--------------------------------------------------------------------------------------------------------------------------
C. Terceiro passo: Após determinar afinidade pelo GRAM e arranjo bacteriano, seguir com os testes para cada grupo: cocos Gram-positivos, bastonetes Gram-negativos. cocobacilos Gram-negativos, bastonetes Gram-positivos.
-Caso esteja diante de Candida spp., fazer o teste do tubo germinativo; ou semear em meio cromogênico para identificação das espécies Candida albicans, Candida tropicalis e Candida krusei.
--------------------------------------------------------------------------------------------------------------------------
Referências bibliográficas:
- Oplustil, C.P.; Zoccoli, C.M.;
Tobouti, N.R.; Sinto, S.I. Procedimentos
Básicos em Microbiologia Clínica, 3ª
Ed. Sarvier, São Paulo, SP, 2010.

Comentários
Postar um comentário
Olá! Comente abaixo sua opinião a respeito do nosso blog, ajudará a manter nosso projeto ativo. Obrigada!